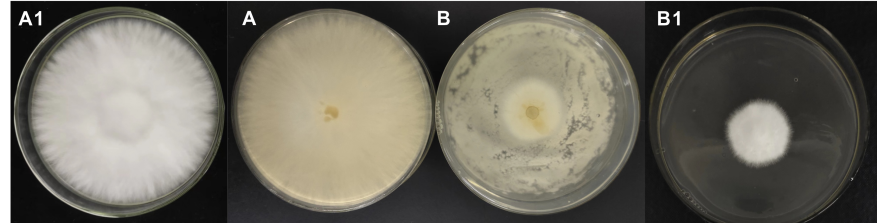

77779193永利(中国)集团杨秀青博士在菇菌互作等方面连续取得重要研究进展
2023-09-07 12:04:52 来源:77779193永利(中国)集团 浏览数:0
77779193永利(中国)集团杨秀青博士利用比较蛋白质组学技术方法,在研究白玉菇与青霉菌相互作用和花脸香蘑生长发育过程方面取得重要进展,被《Food Science and Human Wellness》(中科院分区:1区TOP期刊;IF:7.0)杂志接连接收两篇研究论文,近日,已在中国知网网络首发。“Comparative proteomics reveals the response and adaptation mechanisms of white Hypsizygus marmoreus against the biological stress caused by Penicillium”,揭示了白玉菇在响应青霉菌生物胁迫时存在至少6条作用机制,以及白玉菇应对外部环境改变的2条生长适应机制;另一篇“Comparative proteomics analysis reveals the domesticated Lepista Sordida primordium differentiation regulation mechanism and the subsequent different development patterns in the pileus and stipe“,揭示了花脸香蘑原基分化机制和后续菌盖与菌柄不同发育模式。
青霉菌通过产生有毒气体及通过竞争有限空间和营养等方式抑制白玉菇菌丝生长,该类霉菌易泛滥会导致食用菌工厂化生产较大规模减产。文章1从基因和蛋白表达层面上阐述了白玉菇对青霉菌生物胁迫做出的响应,以及生长过程中为适应受胁迫状态而做出的生长调整,发现6种胁迫响应机制,具体为苯、醛、酚等物质的无毒转化;谷胱甘肽代谢以减少对细胞的氧化损伤;组蛋白修饰,核苷酸切除修复,清除错误折叠蛋白,减少错误核酸和蛋白的形成;将l -赖氨酸转化为食用菌的氮源谷氨酰胺,以应对养分竞争中形成的氮限制;增强过氧化氢酶活性;细胞壁重塑。2种生长适应机制以减少菌丝的生长,包括细胞成分,如核糖体、内质网蛋白质、剪接体等,的减少;碳代谢与产能,如糖酵解和糖异生等,的减弱。
杨秀青博士为该论文第一作者,于浩副教授和刘琳副教授为共同通讯作者,青岛农业大学为唯一通讯单位。本研究得到国家自然科学基金和山东省自然科学基金等项目的资助。中国知网数据库对该文进行了刊登发布(https://kns.cnki.net/kcms2/article/abstract?v=nnFo4n0nVBFh6fZu5uATQtT4-rX0ENe-UhcKPDXR8H5dsBzf7iQyzOvRuJUGEogY8fp286tdo6lziOBShIP77hTEJ2cg2s5c9L3R3w4NeJsachNkrSjsXg==&uniplatform=NZKPT)。

野生花脸香蘑是一种珍稀食药用菌,通过人工驯化获得了一株营养丰富、风味良好、铁含量高的优良菌株,并首次实现了其大规模栽培。文章2利用高通量比较蛋白质组学技术,揭示了该驯化菌株在早期子实体形成过程中原基分化的调控机制,表明原基分化前主要受线粒体功能相关蛋白和调节体内二氧化碳浓度蛋白的影响,原基形成后早期分化主要受与细胞组分生成、细胞增殖、氮化合物代谢、核苷酸代谢、谷胱甘肽代谢和嘌呤代谢相关的蛋白调控。同时,文章还揭示了菌柄和菌盖的不同发育调控模式,调节菌盖生长发育的蛋白主要与转录、RNA剪接和各种细胞器,尤其线粒体膜成分,生成相关,调控菌盖成熟的蛋白主要与DNA构象变化、核小体组织、蛋白质加工、成熟和运输、细胞解毒等过程相关;调节菌柄生长发育的蛋白主要与碳水化合物代谢和能量代谢过程相关,当大量的细胞质部分被废弃,且与营养剥夺和外界刺激相关的蛋白高表达时预示着菌柄的成熟。
杨秀青博士为该论文第一作者,于浩副教授和徐丽丽讲师为共同通讯作者,青岛农业大学为第一通讯单位。本研究得到国家自然科学基金和山东省自然科学基金等项目的资助。中国知网数据库对该文进行了刊登发布(https://kns.cnki.net/kcms2/article/abstract?v=nnFo4n0nVBFh6fZu5uATQtT4-rX0ENe-UhcKPDXR8H5dsBzf7iQyzOvRuJUGEogY4R8DZu1fHqbjt9JrvTG5drLZg8mjnEj9VqD7gjyNPtTNrgQdfUSiog==&uniplatform=NZKPT)。

地址: 邮编:266109
版权所有:77779193永利(中国)集团官网 - Home
联系电话:
鲁ICP备13028537号-5
鲁公网安备 37021402000104号
青岛市互联网违法信息举报中心



